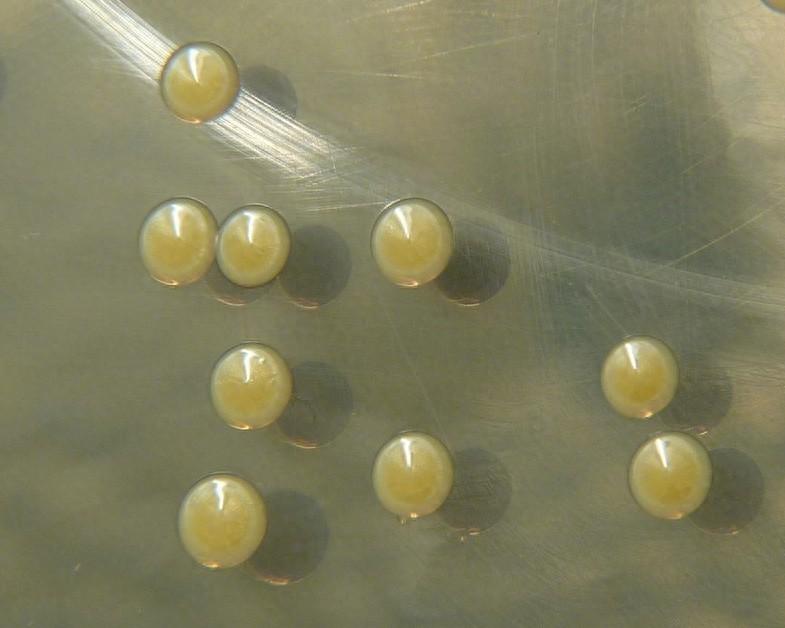

皮膚上的這種真菌,居然可以消滅致命的超級細菌
作品聲明:本文僅在今日頭條發佈,謝絕轉載
作者: Denovo科普團隊(楊超 博士、中國科普作家協會會員)
審覈:劉晨光博士 大連理工大學教授
金黃色葡萄球菌(Staphylococcus aureus)是全球引發皮膚感染、手術併發症甚至敗血症的頭號元兇之一。隨着抗生素的濫用,這種細菌也逐漸演化出耐藥版本,尤其是耐甲氧西林金黃色葡萄球菌(MRSA),更是被世界衛生組織列爲最緊迫威脅之一。
在固體培養基上的金黃色葡萄球菌的菌落(圖片來源:Wikipedia)
在這種背景下,人類正面臨一個殘酷現實,我們開發新抗生素的速度,趕不上細菌進化出抗藥性的速度。然而,一項令人驚訝的最新研究指出,也許我們不必把希望全部寄託在實驗室的培養皿中。我們自己皮膚上的常見真菌,可能正悄悄充當着微型生物工廠,代謝皮膚上的油脂,製造出具有強大殺菌能力的天然分子,對抗那些讓醫生頭疼不已的超級細菌。
馬拉色菌如何把油脂轉化爲武器
如果你對頭皮屑、溼疹等皮膚問題有所耳聞,那你很可能已經聽說過一個名字:馬拉色菌(Malassezia)。這是一類廣泛寄居在人類皮膚表面的酵母型真菌,幾乎在每個人身上都能找到它的蹤跡。儘管它偶爾會引發頭皮屑或皮膚炎症,但大多數時候,它就像一位隱形居民,安分地生活在皮脂分泌豐富的區域,比如頭皮、面部和胸背部。
最近,科學家們卻發現,這位鄰居可能還承擔着守護者的角色。在美國俄勒岡大學的一項研究中,科學家們意外地發現,Malassezia sympodialis 這類馬拉色菌竟然能分泌一種具有強大抗菌作用的脂肪酸分子,在對抗金黃色葡萄球菌方面展現出驚人的能力,相關研究成果發表在《當代生物學》(Current Biology)雜誌上。

發表在《當代生物學》的研究(圖片來源:參考文獻[1])
這一分子被命名爲10-羥基棕櫚酸(10-hydroxy palmitic acid, 10-HPA),是馬拉色菌在代謝皮膚油脂時產生的副產物。它不僅能夠抑制金黃色葡萄球菌在皮膚上的定植,更能在短短15分鐘內將細菌殺死。研究人員在人體皮膚樣本和實驗室共培養實驗中都觀察到了這一抗菌效果。

金黃色葡萄球菌NRS193、大腸桿菌Nissle 或表皮葡萄球菌SK119 在 M. sympodialis、M. furfur或M. pachydermatis 於培養基上共培養生長情況。(圖片來源:參考文獻[1])
更爲關鍵的是,這並非全新發現的化學結構,早在過去的研究中,人們就已識別其存在。但這一次,它以一種全新方式被激活,在模擬人類皮膚的酸性環境中,10-HPA 展現出強烈的抗菌能力,提示我們過去可能因實驗條件不匹配而低估了它的作用潛力。
也就是說,馬拉色菌就像一座藏在皮膚表層的脂質反應工廠,藉助人體分泌的天然油脂,自行合成出一種的抗菌物質,爲我們築起了一道抵禦超級細菌的生物屏障。
脂類代謝 + 酸性環境 = 致命打擊
10-羥基棕櫚酸究竟是如何消滅超級細菌的?首先,10-羥基棕櫚酸的結構類似洗滌劑。它可以深入細菌的細胞膜,並破壞膜結構的完整性。膜一旦被破壞,細菌細胞內的物質就會像氣球漏氣一樣流失,最終導致細菌死亡。這種攻擊方式並不是慢慢毒死細菌,而是直接瓦解它們的“外殼”,來得又快又狠。
然而,更令人驚奇的是,這種殺菌能力並不是在所有條件下都有效。如果你把10-羥基棕櫚酸放進普通的中性實驗液中,它的抗菌活性可能非常弱,甚至不起作用。但一旦置於類似人類皮膚那樣pH約5.5的微酸性環境,它的殺菌威力就會顯著提升。
爲什麼會這樣?這其實與分子在不同pH下的離子狀態有關。在酸性條件下,,10-羥基棕櫚酸的羧基主要以未解離的–COOH形式存在,更加疏水,更容易穿透細菌膜結構發生作用。也就是說,人體皮膚的天然酸性,爲這種天然抗菌物質提供了戰場條件,讓它能高效地發揮作用。
更有趣的是,這種效果似乎是馬拉色菌與皮膚長期共生中共同演化的結果。馬拉色菌不能自己合成脂肪酸,它依賴皮膚油脂爲生,不僅獲取了能量,同時也製造出10-羥基棕櫚酸,保護了皮膚免受細菌侵害——這是一種共生合作的雙贏策略。
研究團隊通過體外實驗進一步證實,在皮脂、低pH和高鹽濃度共同作用下,10-羥基棕櫚酸的殺菌效果最爲顯著。這與人類皮膚的真實環境高度吻合,強化了一個重要結論,我們的皮膚不只是被動抵抗細菌,而是通過真菌—脂類—酸性環境的協同作用,主動構築了一道生物化學防線。
菌與菌的演化博弈——超級細菌也能適應“天然殺手”
10-羥基棕櫚酸的確殺菌迅速,效果顯著。但和所有抗菌物質一樣,它也並非無懈可擊。研究人員在長期共培養實驗中發現,當金黃色葡萄球菌反覆暴露在10-羥基棕櫚酸的環境中後,竟然也能逐步習慣這種攻擊,並發展出耐受性。
這是爲什麼?原來,細菌並不會被動等待命運宣判,它們擁有一套強大的遺傳應激系統。研究人員通過基因測序發現,那些對10-羥基棕櫚酸耐受的菌株中,幾乎都發生了一個共同的突變——Rel基因突變。
Rel基因是細菌中嚴格反應(stringent response)通路的核心成員,它控制着細菌在面對壓力,比如營養匱乏或抗菌攻擊時的生存策略。這個系統會調低細菌的代謝速度、抑制繁殖,並激活一系列應急機制,讓它們進入一種休眠但還活着的狀態,等待環境好轉。

馬拉色菌在皮脂酸性環境中代謝生成10-羥基棕櫚酸能有效殺死金黃色葡萄球菌;但細菌可以適應這一壓力,進化出對10-羥基棕櫚酸與抗生素耐受的突變體。(圖片來源:參考文獻[1])
一旦這個系統被激活,細菌就不再像健康狀態下那樣容易被攻擊。這種以退爲進的策略,使它們對10-羥基棕櫚酸不再那麼敏感。而更令人擔憂的是,這種通過天然抗菌壓力誘導出的應激機制,也會讓細菌對其他臨牀常用抗生素如利福平等出現交叉耐藥性。
換句話說,即便不是人類施加抗生素,自然界中的微生物之間的“化學戰”也可能迫使細菌進化出更強的生存能力,從而間接加劇抗藥性問題。哪怕是從人體真菌中提取的天然抗菌分子,也必須謹慎使用。一旦用於臨牀或皮膚治療中不加節制,仍可能促使細菌加速進化,最終走上耐藥老路。
總結
雖然我們早已熟悉了腸道微生物的多樣性和重要性,但這項研究提醒我們,皮膚上的真菌同樣不可小覷。馬拉色菌不只是與頭皮屑相關的人體問題居民,它還可能是我們對抗有害細菌的天然盟友——通過轉化皮脂生成具有殺菌能力的脂肪酸,參與皮膚健康的防禦體系。
但這也再次警示我們,無論是傳統抗生素,還是來源於微生物的新產物,濫用都有可能加速細菌耐藥性的進化。
參考文獻:
[1] Kowalski, Caitlin H., et al. "Skin mycobiota-mediated antagonism against Staphylococcus aureus through a modified fatty acid." Current Biology (2025).
[2] Sakr, Adèle, et al. "Staphylococcus aureus nasal colonization: an update on mechanisms, epidemiology, risk factors, and subsequent infections." Frontiers in Microbiology 9 (2018): 2419.
[3] Fischer, Carol L., et al. "The roles of cutaneous lipids in host defense." Biochimica et Biophysica Acta (BBA)-Molecular and Cell Biology of Lipids 1841.3 (2014): 319-322.
[4] Zipperer, Alexander, et al. "Human commensals producing a novel antibiotic impair pathogen colonization." Nature 535.7613 (2016): 511-516.
[5] Severn, Morgan M., et al. "The ubiquitous human skin commensal Staphylococcus hominis protects against opportunistic pathogens." MBio 13.3 (2022): e00930-22.


















